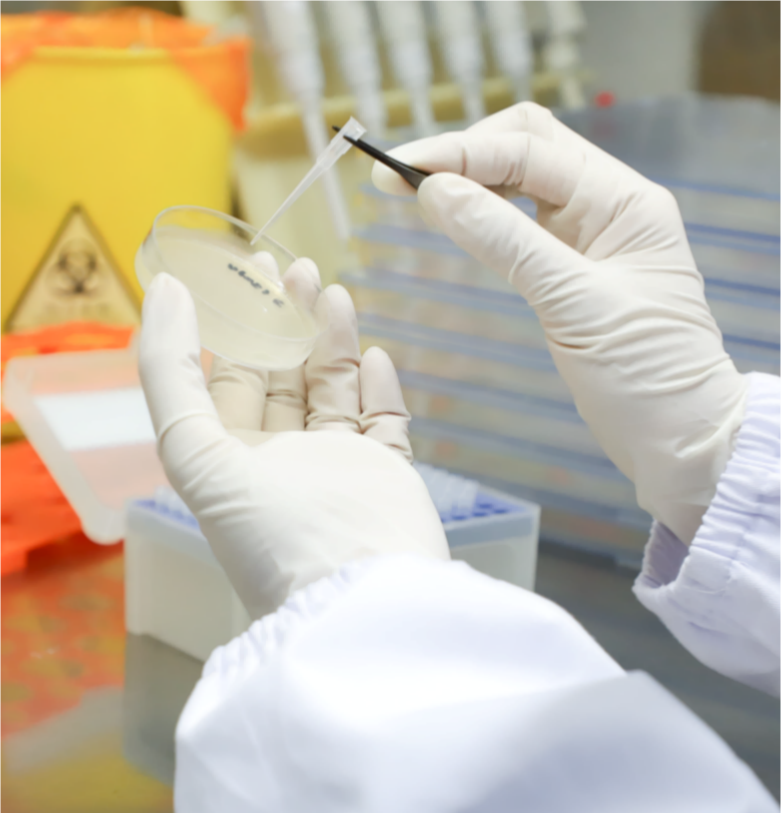
IMG_8998-2.png

Research Institutes
And Laboratories
-
01
GuangDong Engineering Technology Research Center of Microphysiological systems
read more
-
02
Key Laboratory of Molecular Design for Plant Cell Factory of Guangdong Higher Education Institutes
read more
-
03
Key University Laboratory of RNA Medicine of Guangdong
read more
-
04
Shenzhen Key Laboratory Of Gene Regulation And Systems Biology
“Shenzhen Key Laboratory of Gene Regulation and Systems Biology” was established in April 2021 by the School of Life Sciences of Southern University of Science and Technology and is subsidized by Shenzhen Science and Technology Innovation Committee. Our Key Laboratory currently contains 14 independent research groups, constituting a team of more than 80 members, including researchers, postdoctoral fellows, graduate students, visiting scholars, etc. Professor Wei Chen of the School of Life Sciences is the first Director of the Laboratory.
Our Laboratory is committed to developing, utilizing, and integrating state-of-the-art system biology, genomics, single-cell omics, and other technologies for multi-level and multi-dimensional analysis of gene regulation mechanisms. We aim at major scientific issues of life and health, such as stem cell developmental and regenerative medicine, malignant tumorigenesis and metastasis, nervous system diseases, infectious diseases, and new drug discovery, and exploring novel and accurate diagnoses and treatments for the above complex diseases.
read more
-
05
Shenzhen Key Laboratory of Biomolecular Assembling and Regulation
read more
-
06
Shenzhen Key Laboratory of Plant Genetic Engineering and Molecular Design
read more
-
07
SUSTech-PKU Institution of Plant and Food Science
SUSTech-PKU Institution of Plant and Food Science was founded on July 2017 by Shenzhen Municipal Government, SUSTech and Peking University for plant science research and food security technology with the aim at being an top international and national institution of food production with plant science and with industry-university-research system.
read more
-
08
SUSTech-UQ Joint Centre for Neuroscience and Neural Engineering
read more
-
9
Institute for Biological Electron Microscopy
read more
-
10
Innovative Center for RNA Therapeutics(ICRT)
read more
-
01
GuangDong Engineering Technology Research Center of Microphysiological systems
read more
-
02
Key Laboratory of Molecular Design for Plant Cell Factory of Guangdong Higher Education Institutes
read more
-
03
Key University Laboratory of RNA Medicine of Guangdong
read more
-
04
Shenzhen Key Laboratory Of Gene Regulation And Systems Biology
“Shenzhen Key Laboratory of Gene Regulation and Systems Biology” was established in April 2021 by the School of Life Sciences of Southern University of Science and Technology and is subsidized by Shenzhen Science and Technology Innovation Committee. Our Key Laboratory currently contains 14 independent research groups, constituting a team of more than 80 members, including researchers, postdoctoral fellows, graduate students, visiting scholars, etc. Professor Wei Chen of the School of Life Sciences is the first Director of the Laboratory.
Our Laboratory is committed to developing, utilizing, and integrating state-of-the-art system biology, genomics, single-cell omics, and other technologies for multi-level and multi-dimensional analysis of gene regulation mechanisms. We aim at major scientific issues of life and health, such as stem cell developmental and regenerative medicine, malignant tumorigenesis and metastasis, nervous system diseases, infectious diseases, and new drug discovery, and exploring novel and accurate diagnoses and treatments for the above complex diseases.
read more
-
05
Shenzhen Key Laboratory of Biomolecular Assembling and Regulation
read more
-
06
Shenzhen Key Laboratory of Plant Genetic Engineering and Molecular Design
read more
-
07
SUSTech-PKU Institution of Plant and Food Science
SUSTech-PKU Institution of Plant and Food Science was founded on July 2017 by Shenzhen Municipal Government, SUSTech and Peking University for plant science research and food security technology with the aim at being an top international and national institution of food production with plant science and with industry-university-research system.
read more
-
08
SUSTech-UQ Joint Centre for Neuroscience and Neural Engineering
read more
-
9
Institute for Biological Electron Microscopy
read more
-
10
Innovative Center for RNA Therapeutics(ICRT)
read more
Innovative Research Platforms
(Including Key Laboratories and Research Centers)

Biology
Biology Immunology and Microbiology
Immunology and Microbiology Systems Biology
Systems Biology Chemical Biology
Chemical Biology Neuroscience
Neuroscience







